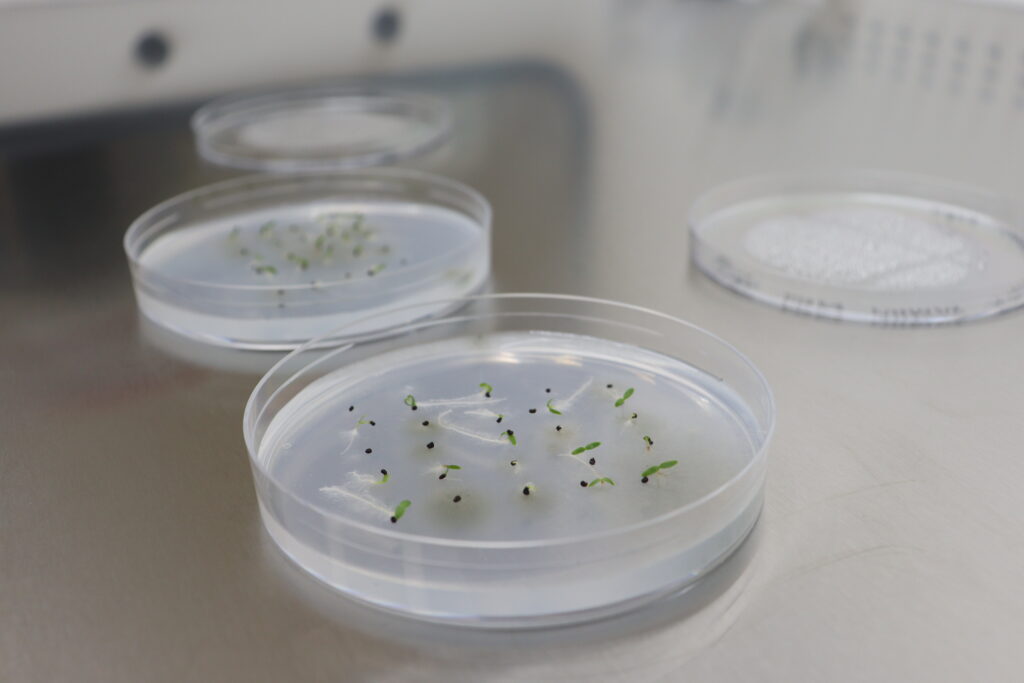

As I recent Biology graduate from the University of Exeter, I was thrilled to return to the Botanic Garden to embark on my new role as Quentin Kay Research & Collections Assistant, and I am now four months in. In 2021-2022, I spent a year as a Science Placement Student at the Garden as part of my degree, which gave me great experience in seed collecting and processing, and collecting Spreading Bellflower, Campanula patula, samples for population genetic analysis. Continuing this work as my first paid position is very exciting, while carrying forward the legacy of esteemed Swansea botanist, Quentin Kay.
I am passionate about nature and conservation, with my main ambition being to contribute to the fight against biodiversity loss worldwide. Plants are vital components of all ecosystems therefore conserving these organisms is crucial for the overall health of our planet.

Importance of the National Seed Bank of Wales
Alarming statistics, such as the Red Data List for Wales estimating that one-sixth of the country’s plants face extinction, underscore the urgency of our conservation efforts. The Botanical Society of Britain and Ireland’s Plant Atlas 2020 project revealed that 40% of plant species in Wales have experienced declines in their distribution since 1950. Seed banking is a vital tool for safeguarding plant species and their genetic diversity for the future. By storing seeds long-term, seed banks serve as an insurance policy, ensuring the availability of seeds from diverse origins for future conservation and research endeavours.
Our focus is the Welsh flora, and as of the start of 2023, our collection in the National Seed Bank of Wales comprised 181 accessions from 101 taxa. But, there is still lots more to be done.
My work so far
In 2023 alone, the Garden made 26 seed collections comprising 20 different species from sites across Wales as part of the Millennium Seed Bank’s UK Threatened Flora Project. This gave us over 100,000 seeds to clean, process, count and quality check, before being stored in the freezer, contributing to our valuable resource of seeds protected for the future. I have been busy cleaning and processing these seed collections, which has involved lots of manual sieving and use of the aspirator machines. It is very rewarding to get pure seed at the end, and sealing the packages for safe storage in the freezer for many years to come.

Additionally, I have been conducting germination tests to assess viability. These tests, a first for our banked collections, will provide valuable insights into the viability of our collections, and importantly, gather initial baseline data to monitor how viability is faring in decades to come. So far, I have set up germination tests for three species from six collections, using our incubators to give the species suitable germination conditions. These species include Prickly Saltwort, Salsola kali, which has shown good germination rates, Nottingham Catchfly, Silene nutans and Tubular Water-dropwort, Oenanthe fistulosa, which have just been sown. Hopefully, in the future, we will be able to incorporate the germination tests into growing plants for a new Welsh flora display in the Botanic Garden.
Another method I have learned for assessing seed viability is tetrazolium testing, a technique that distinguishes live from dead seed by staining living tissues a vibrant pink colour. I was introduced to this method during a demonstration that Kevin McGinn, our Curator for Seed Bank and Herbarium, organised for Project Seagrass with seagrass seeds. Since then, I’ve successfully tested two additional species: Shore Dock, Rumex rupestris, and the pondweed Potamogeton × griffithii.
Ensuring the completeness and accuracy of our seed bank records has been another important aspect of my role, including updating IrisBG, our collections management software, with all of the relevant documentation, such as landowner permission forms and conservation site consents. A thorough stock check of both the fridge and freezers in the Seed Bank have been carried out to ensure that everything is in order, and all records are up to date and accurate. Getting to grips with using IrisBG software has also been a steep learning curve, but I’m happy to say that I am now getting the hang of things.
I have also been helping to organise engagement activities for Science Week, where the Science Team will share insights into the Herbarium and Seed Bank, including activities about seed dispersal mechanisms. I’ll also be delivering a presentation on International Women’s Day, highlighting the impactful work undertaken in my new role.
Work to come
Looking ahead, my next challenge involves planning fieldwork for this year’s seed collections, which entails identifying target species, determining optimal seed collection sites and securing landowner and conservation site permissions. We will be contributing to projects run by the Millennium Seed Bank, including collecting seeds from a variety of native tree species, in addition to making collections from crop wild relatives, many species of which we have here at the Botanic Garden in Waun Las NNR. I am very much looking forward to getting out in the field on collecting trips and seeing these plants in the wild.
In summary, my journey as a Research & Collections Assistant has been a big learning curve delving into the world of plants and taking active conservation action to preserve them. I’m thrilled to play a role in ensuring the enduring survival of Welsh flora for generations to come!

Ellyn has written this blog for British Science Week and International Women’s Day as part of the Botanic Garden’s Plants Past, Present and Future project, funded by the National Lottery Heritage Fund.